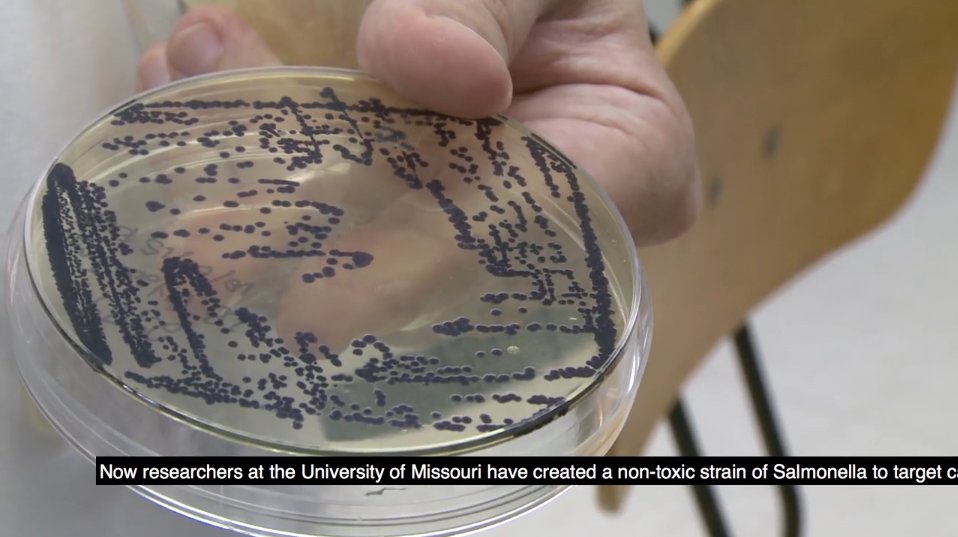
Researchers are testing salmonella as a possible cancer treatment wef.ch/2dO5JZn

D'Angelo K. Merritt
@d_k_merritt
An observant Trini who calls it as he sees it.
ID: 134583434
18-04-2010 21:29:39
698 Tweet
55 Followers
291 Following
















3.14159265358979323846264338327950—you need thirty-three digits of pi before a zero shows up. John Allen Paulos, why so many?